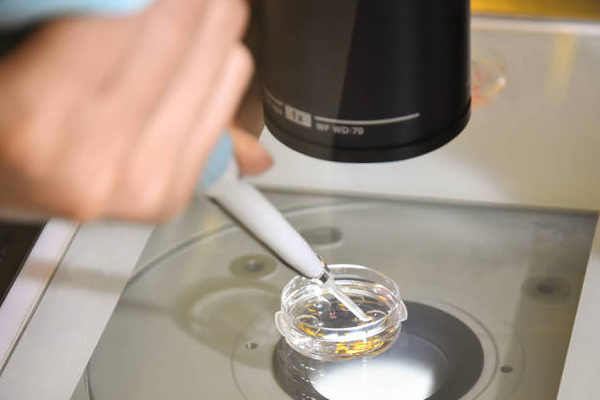
e087d111583db4b20fb868a065f4faed.png 美国第三代试管婴儿技术怎么样

美国第三代试管婴儿技术,即植入前遗传学诊断(PGT),在全球享有盛誉。那么,关于这项技术,美国第三代试管婴儿技术排名?如何选择美国试管婴儿医院?本文將為您詳細解析這兩個問題,幫助您更好地瞭解美國試管嬰兒技術的現狀與選擇策略。
美国第三代试管婴儿技术怎么样?
美国的三代试管技术已经非常成熟,涉及体外受精、胚胎培养、遗传学检测和胚胎移植等多个环节,每个步骤都经过严格把控。特別是PGD/PGS技術的應用,使得醫生能夠在移植前篩選健康胚胎,顯著提高试管婴儿的成功率和胚胎质量。
美国三代试管技术的成功率在全球处于领先,整体成功率可达60%至80%,在一些优质医疗机构中甚至更高。这一高成功率得益于先进的医疗技术、高水平的医疗团队和优越的医疗环境。
美国第三代试管婴儿医院怎么选?
1.专业资质与认证:确认医院具备相关专业资质和认证,例如美国生殖医学协会(ASRM)和美国病理学家协会(CAP)的认证,以保证医院的专业性和服务质量。
2.医生团队与经验:医生的专业背景、临床經驗和成功案例是影響三代試管嬰兒成功率的重要因素,醫生的知識和技術直接關係到治療效果和患者体验。
3.地理位置与交通便利性:由于三代试管婴儿治疗需要多次往返医院,选择一个距离较近或交通方便的医院可以减少旅途疲劳,提高治疗效率。医院提供的住宿和餐饮服务也能减轻患者的负担。
4.服务态度与患者关怀:积极的心态对提高成功率至關重要,醫院應關注患者心理健康,提供舒適的治療環境和細緻的關懷服務。
5.治疗方案与个性化服务:医院需根据患者的年龄、身体状况和病史,提供个性化的治疗方案,以提高成功率和患者满意度。
6.费用与透明度:了解医院的收费标准、是否包含所有必要的檢查和治療,以及是否存在隱藏費用。醫院應提供清晰的費用清單,讓患者明白每项费用的具体用途。
美国第三代试管婴儿医生怎么选?
1.经验:经验丰富的医生能为患者提供更好的保障。选择试管婴儿手术时,患者应了解医生的履历,特别是其在辅助生殖方面的经验,以及是否曾为名人提供IVF服务,但这部分信息通常较为隐私。
2.口碑:患者应多方面了解医生的口碑,网上的评价可以作为参考。通常,口碑良好的医生在试管婴儿技术上更为出色。

3.方案:不同医生的服务和风格各异。有些醫生可能會套用固定方案,而優秀的醫生會根據患者的具體數據和實際情況制定個性化方案。
上文介绍美国第三代试管婴儿技术排名?如何选择美国试管婴儿医院?等情况。选择美国试管婴儿医院需要综合考虑医院资质、医疗技术、胚胎实验室条件以及医生团队的專業素養。同時,瞭解醫院的成功案例和患者回饋也是非常重要的。
